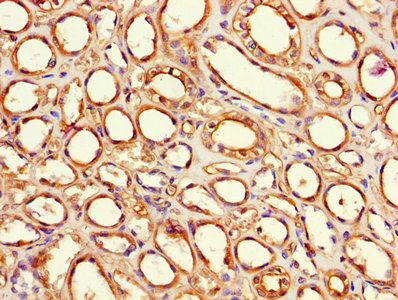
CSB-PA007932LA01HU

F8
F8,即凝血因子VIII,它是一種在肝臟合成的血漿糖蛋白,由F8基因編碼。F8在凝血過程中發揮關鍵作用,作為凝血因子IXa的輔因子,參與凝血因子X的激活,從而促進血液凝固。F8的來源主要是肝細胞,成熟的F8由2332個氨基酸組成,分子量約為300 kDa。F8的生物學意義在于維持血液凝固和止血平衡,缺乏或功能異常的F8會導致血友病A等出血性疾病。
熱銷產品
Recombinant Human Coagulation factor VIII (F8) (CSB-EP007932HU)
驗證數據

(Tris-Glycine gel) Discontinuous SDS-PAGE (reduced) with 5% enrichment gel and 15% separation gel.
F8 Antibody (CSB-PA007932LA01HU)
驗證數據

Immunohistochemistry of paraffin-embedded human placenta tissue using CSB-PA007932LA01HU at dilution of 1:100
Immunohistochemistry of paraffin-embedded human kidney tissue using CSB-PA007932LA01HU at dilution of 1:100

Immunofluorescent analysis of Hela cells using CSB-PA007932LA01HU at dilution of 1:100 and Alexa Fluor 488-congugated AffiniPure Goat Anti-Rabbit IgG(H+L)
F8 Antibodies
F8 for Homo sapiens (Human)
| 產品貨號 | 產品名稱 | 種屬反應性 | 應用類型 |
|---|---|---|---|
| CSB-PA007932GA01HU | F8 Antibody | Human | ELISA,IF |
| CSB-PA002462 | F8 Antibody | Human,Mouse | WB, IHC, ELISA |
| CSB-PA007932LA01HU | F8 Antibody | Human | ELISA, IHC, IF |
| CSB-PA007932LB01HU | F8 Antibody, HRP conjugated | Human | ELISA |
| CSB-PA007932LC01HU | F8 Antibody, FITC conjugated | Human | |
| CSB-PA007932LD01HU | F8 Antibody, Biotin conjugated | Human | ELISA |
F8 Proteins
F8 Proteins for Sus scrofa (Pig)
| 產品貨號 | 產品名稱 | 來源 |
|---|---|---|
| CSB-YP007932PI CSB-BP007932PI CSB-MP007932PI CSB-EP007932PI-B |
Recombinant Pig Coagulation factor VIII (F8), partial | Yeast Baculovirus Mammalian cell In Vivo Biotinylation in E.coli |
F8 Proteins for Homo sapiens (Human)
| 產品貨號 | 產品名稱 | 來源 |
|---|---|---|
| CSB-YP007932HU CSB-BP007932HU CSB-MP007932HU CSB-EP007932HU-B |
Recombinant Human Coagulation factor VIII (F8) | Yeast Baculovirus Mammalian cell In Vivo Biotinylation in E.coli |
| CSB-EP007932HU | Recombinant Human Coagulation factor VIII (F8) | E.coli |
F8 Proteins for Canis familiaris (Dog) (Canis lupus familiaris)
| 產品貨號 | 產品名稱 | 來源 |
|---|---|---|
| CSB-YP007932DO CSB-EP007932DO CSB-BP007932DO CSB-MP007932DO CSB-EP007932DO-B |
Recombinant Dog Coagulation factor VIII (F8), partial | Yeast E.coli Baculovirus Mammalian cell In Vivo Biotinylation in E.coli |
F8 ELISA Kit
F8 ELISA Kit for Homo sapiens (Human)
| 產品貨號 | 產品名稱 | 樣本類型 | 靈敏度 |
|---|---|---|---|
| CSB-E13861h | Human coagulation factor VIII (FVⅢ) ELISA Kit | serum, plasma, tissue homogenates | 3.125 ng/ml. |
F8 ELISA Kit for Mus musculus (Mouse)
| 產品貨號 | 產品名稱 | 樣本類型 | 靈敏度 |
|---|---|---|---|
| CSB-E13084m | Mouse coagulation factor Ⅷ(FⅧ) ELISA Kit | serum, plasma | 0.078 ng/mL |
F8 ELISA Kit for Sus scrofa (Pig)
| 產品貨號 | 產品名稱 | 樣本類型 | 靈敏度 |
|---|---|---|---|
| CSB-E15000p | Pig coagulation factor VIII(FVIII) ELISA Kit | serum, plasma, tissue homogenates | 15.62 ng/mL |











